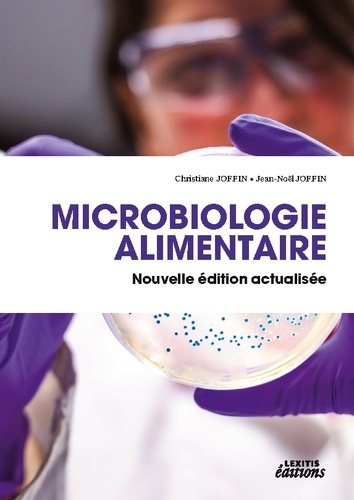
Microbiologie alimentaire

Universitaires
-
 Bioch. Biochimie, 3e édition 22,26 €
Bioch. Biochimie, 3e édition 22,26 € -
Microbiologie alimentaire 89,05 €
Microbiologie alimentaire 89,05 € -
 La maison des mathématiques 26,49 €
La maison des mathématiques 26,49 € -
 THE HOUSE OF MATHEMATICS 26,49 €
THE HOUSE OF MATHEMATICS 26,49 €
































